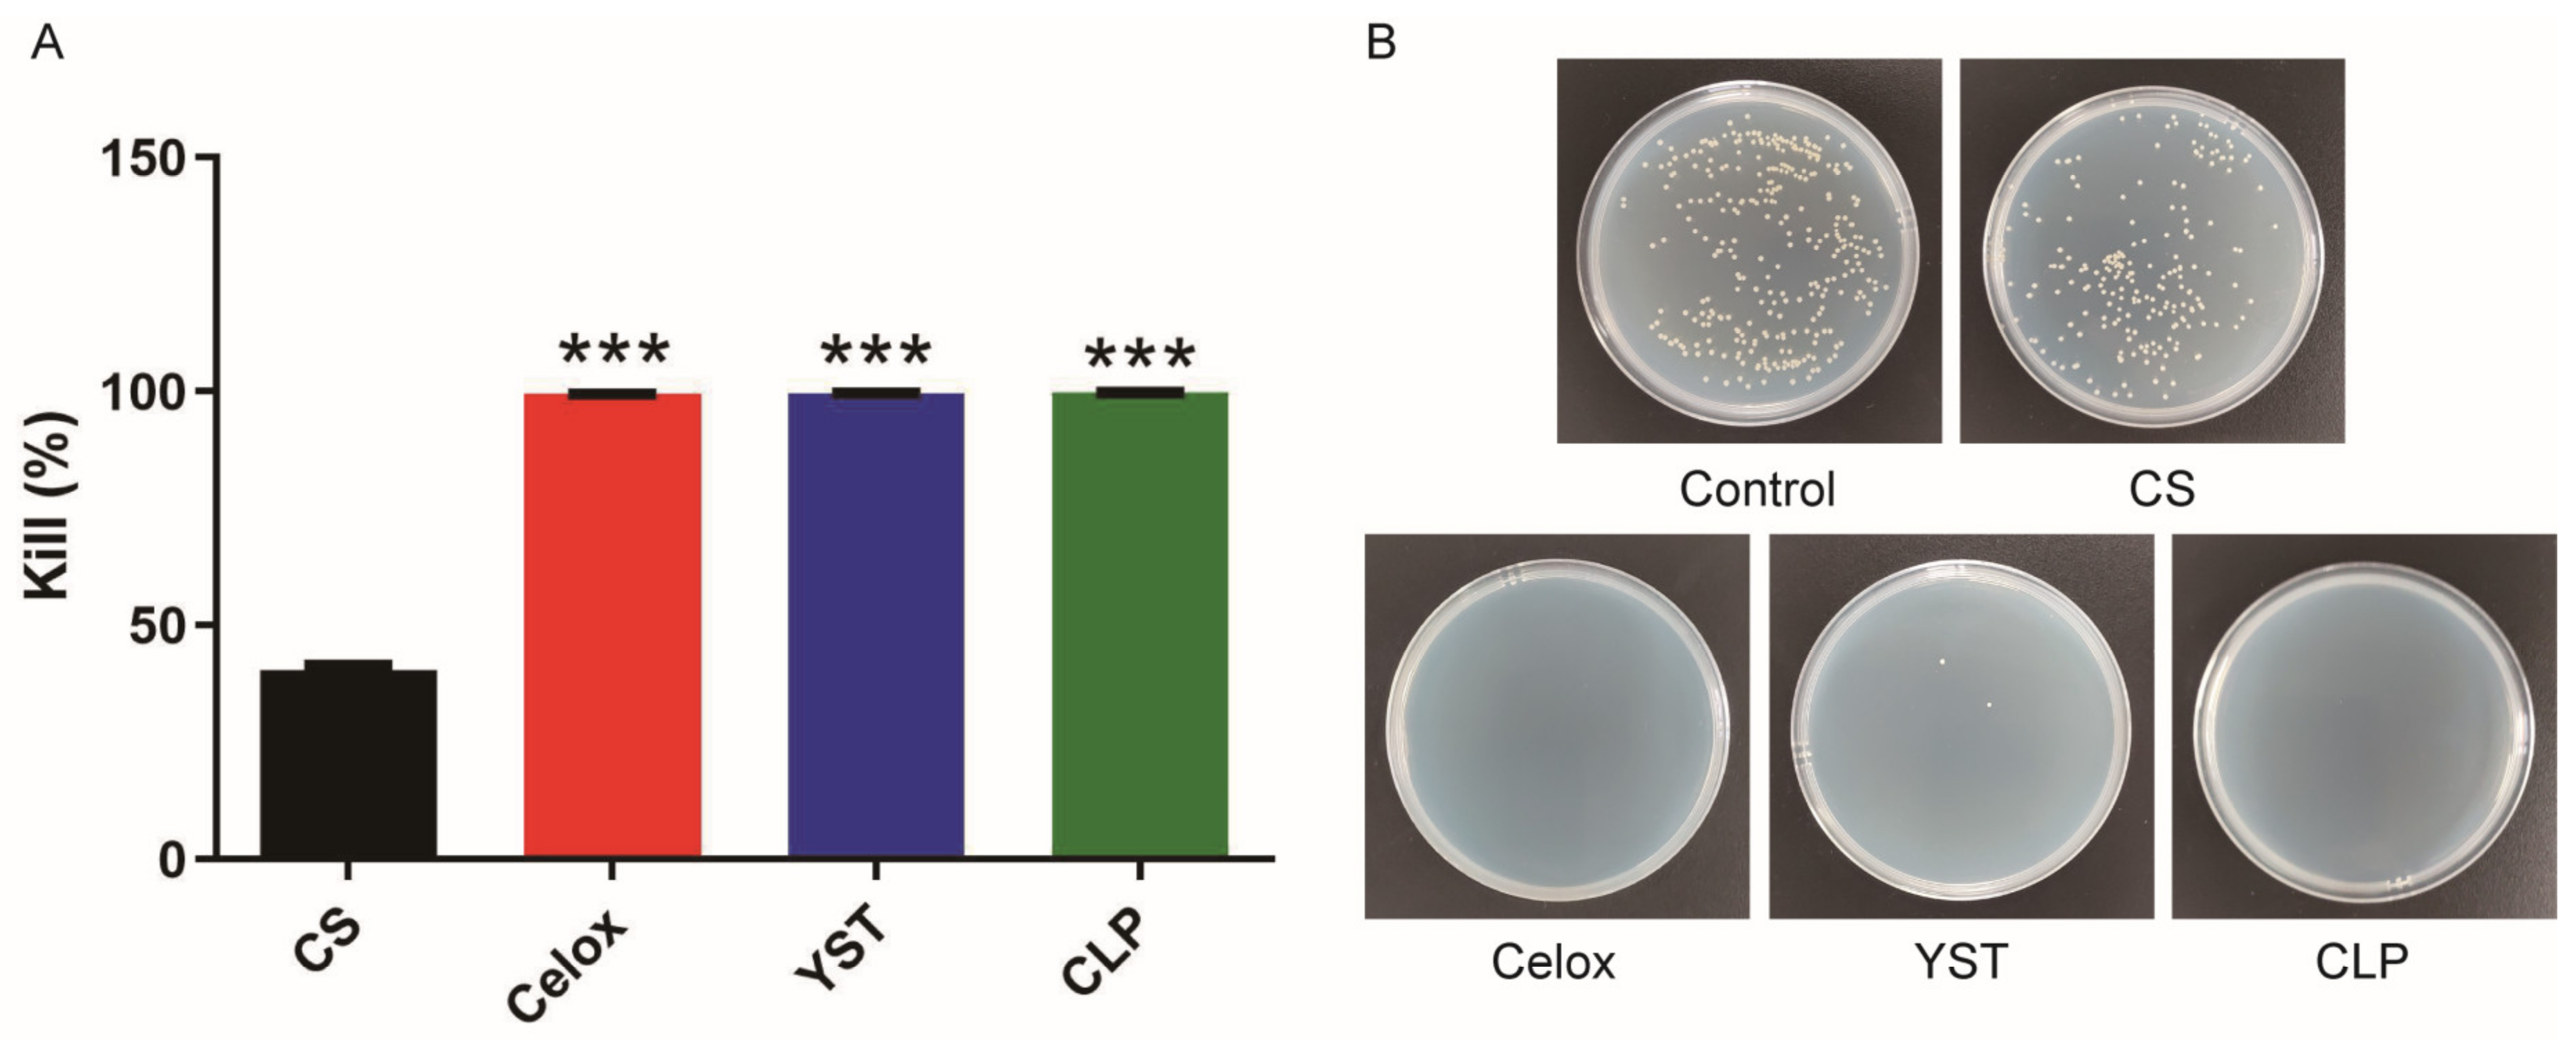
Polymers 15 00656 g002 Polymers 15 00656 g002

Chitosan Lactate Particles for Non-Compression Hemostasis on Hepatic Resection
Abstract
1. Introduction
2. Materials and Methods
2.1. Chitosan
- C1, HCl standard solution concentration (mol/L);
- C2, NaOH standard solution concentration (mol/L);
- V1, drop the HCl standard solution volume (mL);
- V2, consume NaOH standard solution volume (mL);
- G, sample weight (g);
- W, sample moisture content (%);
- 0.016, amount of amine equivalent to 1 mL of 1 mol/L HCl (g);
- 0.094, theoretical amine group content in chitosan.
2.2. Preparation of Chitosan Lactate Particles (CLP)
2.3. Particles Morphology, Size and Zeta Potential Analysis
2.4. Cytotoxicity
- Asample: absorbance values of the cells treated with the sample extract.
- Acontrol: absorbance values after treatment of cells with basal medium.
2.5. Hemolysis Evaluation
- Asample: absorbance values after sample treatment.
- Anegative: absorbance values after normal saline treatment.
- Apositive: absorbance values after distilled water treatment.
2.6. Antimicrobial Test
- NC: the number of bacterial colonies in the control group.
- NE: the number of bacterial colonies surviving in the experiment group.
2.7. Liquid Absorption
- Wwet: the wet weight of the sample.
- Wdry: the dry weight of the sample.
2.8. In Vitro Blood Coagulation Test
2.9. Red Blood Cells (RBCs) Adhesion Test
- ODhemostat: the OD540 nm value after the hemostat treatment.
- ODreference: the OD540 nm value without the hemostatic agent treatment.
2.10. Platelets Adhesion Test
- ODhemostat: the OD490 nm value after the hemostat treatment.
- ODreference: the OD490 nm value without the hemostatic agent treatment.
2.11. Hemostatic Test In Vivo
2.12. Statistics and Reproducibility
3. Results and Discussions
3.1. Preparation and Characterization
3.2. Biocompatibility
3.3. Anti-Infection Properties In Vitro
3.4. Capacity of Liquid/Blood Absorption
3.5. In Vitro Procoagulability
3.6. Hemostatic Effects of CLP In Vivo
4. Conclusions
Author Contributions
Funding
Institutional Review Board Statement
Data Availability Statement
Acknowledgments
Conflicts of Interest
References
- Cross, A.J.; Connor, S.J. Hemostasis and thrombosis in major liver resection. Semin. Thromb. Hemost. 2015, 41, 99–107. [Google Scholar] [CrossRef] [PubMed]
- Huntington, J.T.; Royall, N.A.; Schmidt, C.R. Minimizing blood loss during hepatectomy: A literature review. J. Surg. Oncol. 2014, 109, 81–88. [Google Scholar] [CrossRef] [PubMed]
- Eeson, G.; Karanicolas, P.J. Hemostasis and Hepatic Surgery. Surg. Clin. N. Am. 2016, 96, 219–228. [Google Scholar] [CrossRef] [PubMed]
- Huang, T.; Zhou, Z.; Li, Q.; Tang, X.; Chen, X.; Ge, Y.; Ling, J. Light-Triggered Adhesive Silk-Based Film for Effective Photodynamic Antibacterial Therapy and Rapid Hemostasis. Front. Bioeng. Biotechnol. 2022, 9, 820434. [Google Scholar] [CrossRef]
- Stellingwerff, M.; Brandsma, A.; Lisman, T.; Porte, R.J. Prohemostatic Interventions in Liver Surgery. Semin. Thromb. Hemost. 2012, 38, 244–249. [Google Scholar] [CrossRef]
- Gandini, A.; Melodelima, D.; Schenone, F.; N’Djin, A.W.; Chapelon, J.Y.; Rivoire, M. High-intensity focused ultrasound (HIFU)-assisted hepatic resection in an animal model. Ann. Surg. Oncol. 2012, 19 (Suppl. 3), S447–S454. [Google Scholar] [CrossRef]
- Ayav, A.; Bachellier, P.; Habib, N.A.; Pellicci, R.; Tierris, J.; Milicevic, M.; Jiao, L.R. Impact of radiofrequency assisted hepatectomy for reduction of transfusion requirements. Am. J. Surg. 2007, 193, 143–148. [Google Scholar] [CrossRef]
- Crispi, C.P.; Crispi, C.P., Jr.; da Silva Reis, P.S., Jr.; Mendes, F.L.F.; Filgueiras, M.M.; de Freitas Fonseca, M. Hemostasis with the Ultrasonic Scalpel. JSLS 2018, 22, e2018.00042. [Google Scholar] [CrossRef]
- Komorowski, A.L.; Lukashenko, A.; Chang, Y.C. The past and present of liver suture. World J. Surg. 2014, 38, 512–518. [Google Scholar] [CrossRef]
- Ozer, M.T.; Eryilmaz, M.; Coskun, K.; Demirbas, S.; Uzar, A.I.; Kozak, O. A new method for hepatic resection and hemostasis: Absorbable plaque and suture. Eurasian J. Med. 2010, 42, 1–4. [Google Scholar] [CrossRef]
- Su, H.; Wei, S.; Chen, F.; Cui, R.; Liu, C. Tranexamic acid-loaded starch hemostatic microspheres. RSC Adv. 2019, 9, 6245–6253. [Google Scholar] [CrossRef] [PubMed]
- Lewis, K.M.; Atlee, H.; Mannone, A.; Lin, L.; Goppelt, A. Efficacy of hemostatic matrix and microporous polysaccharide hemospheres. J. Surg. Res. 2015, 193, 825–830. [Google Scholar] [CrossRef] [PubMed]
- Liu, D.; Nikoo, M.; Boran, G.; Zhou, P.; Regenstein, J.M. Collagen and gelatin. Annu. Rev. Food Sci. Technol. 2015, 6, 527–557. [Google Scholar] [CrossRef] [PubMed]
- Yang, X.; Liu, W.; Li, N.; Wang, M.; Liang, B.; Ullah, I.; Neve, A.L.; Feng, Y.; Chen, H.; Shi, C. Design and development of polysaccharide hemostatic materials and their hemostatic mechanism. Biomater. Sci. 2017, 5, 2357–2368. [Google Scholar] [CrossRef] [PubMed]
- Sonin, D.; Pochkaeva, E.; Zhuravskii, S.; Postnov, V.; Korolev, D.; Vasina, L.; Kostina, D.; Mukhametdinova, D.; Zelinskaya, I.; Skorik, Y.; et al. Biological safety and biodistribution of chitosan nanoparticles. Nanomaterials 2020, 10, 810. [Google Scholar] [CrossRef]
- Tang, X.; Gu, X.; Wang, Y.; Chen, X.; Ling, J.; Yang, Y. Stable antibacterial polysaccharide-based hydrogels as tissue adhesives for wound healing. RSC Adv. 2020, 10, 17280–17287. [Google Scholar] [CrossRef] [PubMed]
- Muxika, A.; Etxabide, A.; Uranga, J.; Guerrero, P.; De La Caba, K. Chitosan as a bioactive polymer: Processing, properties and applications. Int. J. Biol. Macromol. 2017, 105 Pt 2, 1358–1368. [Google Scholar] [CrossRef]
- Wang, W.; Meng, Q.; Li, Q.; Liu, J.; Zhou, M.; Jin, Z.; Zhao, K. Chitosan Derivatives and Their Application in Biomedicine. Int. J. Mol. Sci. 2020, 21, 487. [Google Scholar] [CrossRef]
- Yang, G.; Hou, X.; Lu, J.; Wang, M.; Wang, Y.; Huang, Y.; Liu, Q.; Liu, S.; Fang, Y. Enzymatic modification of native chitin and chitin oligosaccharides by an alkaline chitin deacetylase from Microbacterium esteraromaticum MCDA02. Int. J. Biol. Macromol. 2022, 203, 671–678. [Google Scholar] [CrossRef]
- Zhang, W.; Jin, X.; Li, H.; Zhang, R.R.; Wu, C.W. Data on the experiments of temperature-sensitive hydrogels for pH-sensitive drug release and the characterizations of materials. Data Brief 2018, 17, 419–423. [Google Scholar] [CrossRef]
- Kasaai, M.R. Various methods for determination of the degree of N-acetylation of chitin and chitosan: A review. J. Agric. Food Chem. 2009, 57, 1667–1676. [Google Scholar] [CrossRef]
- Tang, X.; Chen, X.; Zhang, S.; Gu, X.; Wu, R.; Huang, T.; Zhou, Z.; Sun, C.; Ling, J.; Liu, M.; et al. Silk-Inspired In Situ Hydrogel with Anti-Tumor Immunity Enhanced Photodynamic Therapy for Melanoma and Infected Wound Healing. Adv. Funct. Mater. 2021, 31, 2101320. [Google Scholar] [CrossRef]
- Du, X.; Wu, L.; Yan, H.; Jiang, Z.; Li, S.; Li, W.; Bai, Y.; Wang, H.; Cheng, Z.; Kong, D.; et al. Microchannelled alkylated chitosan sponge to treat noncompressible hemorrhages and facilitate wound healing. Nat. Commun. 2021, 12, 4733. [Google Scholar] [CrossRef] [PubMed]
- Guo, Y.; Wang, Y.; Zhao, X.; Li, X.; Wang, Q.; Zhong, W.; Mequanint, K.; Zhan, R.; Xing, M.; Luo, G. Snake extract-laden hemostatic bioadhesive gel cross-linked by visible light. Sci. Adv. 2021, 7, eabf9635. [Google Scholar] [CrossRef] [PubMed]
- Pan, G.; Li, F.; He, S.; Li, W.; Wu, Q.; He, J.; Ruan, R.; Xiao, Z.; Zhang, J.; Yang, H. Mussel- and Barnacle Cement Proteins-Inspired Dual-Bionic Bioadhesive with Repeatable Wet-Tissue Adhesion, Multimodal Self-Healing, and Antibacterial Capability for Nonpressing Hemostasis and Promoted Wound Healing. Adv. Funct. Mater. 2022, 32, 2200908. [Google Scholar] [CrossRef]
- Li, M.; Zhang, Z.; Liang, Y.; He, J.; Guo, B. Multifunctional Tissue-Adhesive Cryogel Wound Dressing for Rapid Nonpressing Surface Hemorrhage and Wound Repair. ACS Appl. Mater. Interfaces 2020, 12, 35856–35872. [Google Scholar] [CrossRef] [PubMed]
- Zhao, X.; Guo, B.; Wu, H.; Liang, Y.; Ma, P.X. Injectable antibacterial conductive nanocomposite cryogels with rapid shape recovery for noncompressible hemorrhage and wound healing. Nat. Commun. 2018, 9, 2784. [Google Scholar] [CrossRef] [PubMed]
- Wang, C.; Niu, H.; Ma, X.; Hong, H.; Yuan, Y.; Liu, C. Bioinspired, Injectable, Quaternized Hydroxyethyl Cellulose Composite Hydrogel Coordinated by Mesocellular Silica Foam for Rapid, Noncompressible Hemostasis and Wound Healing. ACS Appl. Mater. Interfaces 2019, 11, 34595–34608. [Google Scholar] [CrossRef]
- Huang, Y.; Zhao, X.; Zhang, Z.; Liang, Y.; Yin, Z.; Chen, B.; Bai, L.; Han, Y.; Guo, B. Degradable Gelatin-Based IPN Cryogel Hemostat for Rapidly Stopping Deep Noncompressible Hemorrhage and Simultaneously Improving Wound Healing. Chem. Mater. 2020, 32, 6595–6610. [Google Scholar] [CrossRef]
- Yang, X.; Liu, W.; Shi, Y.; Xi, G.; Wang, M.; Liang, B.; Feng, Y.; Ren, X.; Shi, C. Peptide-immobilized starch/PEG sponge with rapid shape recovery and dual-function for both uncontrolled and noncompressible hemorrhage. Acta Biomater. 2019, 99, 220–235. [Google Scholar] [CrossRef] [PubMed]

Disclaimer/Publisher’s Note: The statements, opinions and data contained in all publications are solely those of the individual author(s) and contributor(s) and not of MDPI and/or the editor(s). MDPI and/or the editor(s) disclaim responsibility for any injury to people or property resulting from any ideas, methods, instructions or products referred to in the content. |
© 2023 by the authors. Licensee MDPI, Basel, Switzerland. This article is an open access article distributed under the terms and conditions of the Creative Commons Attribution (CC BY) license (https://creativecommons.org/licenses/by/4.0/).
Share and Cite
Jiang, Y.; Tang, X.; Li, T.; Ling, J.; Ge, Y.; Yang, Y. Chitosan Lactate Particles for Non-Compression Hemostasis on Hepatic Resection. Polymers 2023, 15, 656. https://doi.org/10.3390/polym15030656
Jiang Y, Tang X, Li T, Ling J, Ge Y, Yang Y. Chitosan Lactate Particles for Non-Compression Hemostasis on Hepatic Resection. Polymers. 2023; 15(3):656. https://doi.org/10.3390/polym15030656
Chicago/Turabian StyleJiang, Yuhui, Xiaoxuan Tang, Tao Li, Jue Ling, Yifan Ge, and Yumin Yang. 2023. "Chitosan Lactate Particles for Non-Compression Hemostasis on Hepatic Resection" Polymers 15, no. 3: 656. https://doi.org/10.3390/polym15030656
APA StyleJiang, Y., Tang, X., Li, T., Ling, J., Ge, Y., & Yang, Y. (2023). Chitosan Lactate Particles for Non-Compression Hemostasis on Hepatic Resection. Polymers, 15(3), 656. https://doi.org/10.3390/polym15030656






